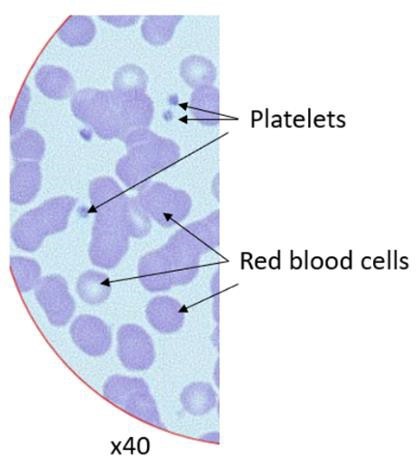
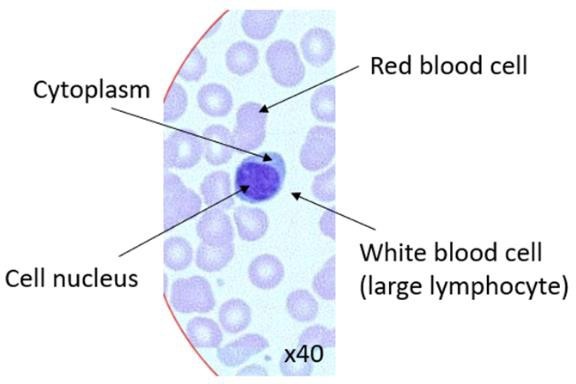

Appendix 2: Teacher notes – output of the lesson (The structure of eukaryotic cells)
Appendix 2: Teacher notes – output of the lesson (The structure of eukaryotic cells)
Because of their size and the resolution limit of a light microscope, it will not be possible to see all of the organelles in a cell. A discussion point might be to consider the width of a cell membrane and that organelles are membrane bound structures – the bilayer structure of the cell membrane can only be visualised using an electron microscope. Ask your students, based on their observations using the virtual microscope, why it is possible to see some organelles and not others.
The animal cell slides include:- Cheek cells
- Skeletal muscle tissue
- Human blood cells (a normal blood smear; sickle cell anaemia blood smear).
- Onion root
- Nymphaea (lily leaf).
Below is a series of labelled images captured using the virtual microscope:
|
Human cheek cell |
|
|
|
Skeletal muscle – consists of muscle fibres that are long, thin cells, containing many cell nuclei throughout their length. Other cells types are also present, such as fat cells (adipose cells), endothelial cells that line the blood vessels and blood cells. |
|
|
|
|
|
|
|
Blood cells – Seven different types of cells can be identified in the blood smear. Ask your students to consider the different distributions for each cell type. |
|
|
|
|
|
|
|
|
|
|
|
Onion root – ask your students where dividing cells can be found and the significance of their location (hint – cell growth and extension at the root tip). |
|
|
|
|
|
Nymphaea (lily leaf) – ask your students to think about which parts of the leaf are facing the sun and how the structure is adapted for the purposes of photosynthesis. |
|
|
|
|
|
|